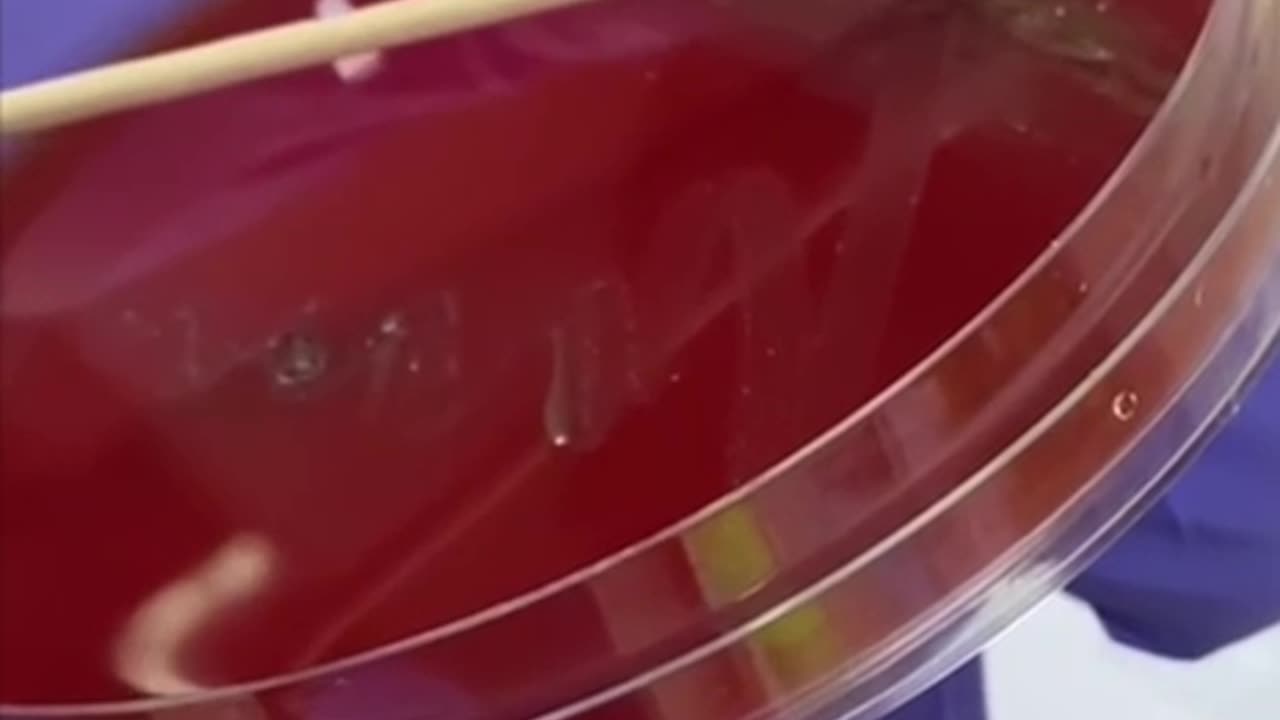
“食安危機揭露”已有60年歷史的義大利知名品牌Nutella，產品有巧力克醬、榛子醬、巧克力榛子醬等，深受全世界歡迎！但用“高倍顯微鏡”沾一點點醬看到它含有大量“微生物（寄生蟲）”

Premium Only Content
This video is only available to Rumble Premium subscribers. Subscribe to
enjoy exclusive content and ad-free viewing.
“食安危機揭露”已有60年歷史的義大利知名品牌Nutella,產品有巧力克醬、榛子醬、巧克力榛子醬等,深受全世界歡迎!但用“高倍顯微鏡”沾一點點醬看到它含有大量“微生物(寄生蟲)”
1 year ago
150
Mar.19.2024
*Nutella 花生醬品牌的介紹:
https://en.m.wikipedia.org/wiki/Nutella
(感謝 HATSTRUTH 🎩頻道公開影片訊息)
Loading 1 comment...
-

Game On!
19 hours ago $11.51 earnedNFL Week 13 Preview And BEST BETS!
52.2K1 -
 29:09
29:09
Forrest Galante
15 hours agoI Caught a 400lb Prehistoric Fish!
107K9 -
 16:32
16:32
Blackstone Griddles
14 hours agoEpisode 13 | Breakfast, Lunch, and Dinner
49.5K2 -
 LIVE
LIVE
Lofi Girl
3 years agolofi hip hop radio 📚 - beats to relax/study to
532 watching -
 55:36
55:36
The Bold Lib
14 hours agoLilly Gaddis: BOLDTALK W/Angela Belcamino
14.8K3 -
 23:42
23:42
The Kevin Trudeau Show Limitless
2 days agoThe Brotherhood’s Ancient Mirror Code Revealed
66.7K22 -
 LIVE
LIVE
DynastyXL
3 hours ago🔴 FORTNITE LIVE EVENT COUNTDOWN
188 watching -
 LIVE
LIVE
Phyxicx
14 hours agoFinal Fantasy 8 Disc 3 & 4! - 11/28/2025
199 watching -
 12:41
12:41
Demons Row
14 hours ago $3.34 earned200 Cops Just Raided 40 Biker Club Houses… The Truth Is INSANE 💀🚨
16.6K16 -
 LIVE
LIVE
FyrBorne
13 hours ago🔴Battlefield REDSEC Live M&K Gameplay: The SCAR Will Leave You SOR
112 watching